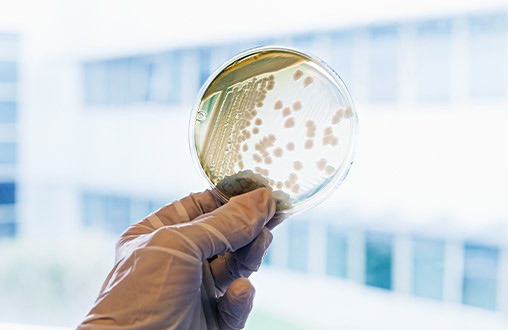

Notícias recentes
Algodão
Algodão no Brasil registra alta e atinge maior preço em 9 meses, aponta Cepea
Preço do algodão atinge maior nível em 9 meses no Brasil, impulsionado por mercado internacional e entressafra, aponta Cepea.
PorIuri Castromaio 1, 2026 12:25Preço do algodão se aproxima de R$ 4/lp no Brasil com mercado firme e baixa liquidez
Preço do algodão se aproxima de R$ 4/lp no Brasil, sustentado por vendedores firmes e mercado externo, enquanto liquidez segue limitada.
PorIuri Castroabril 23, 2026 11:00Safras & Mercado estima queda de 11,5% na produção de algodão no Brasil para safra 2025/26
Safras & Mercado projeta queda de 11,5% na produção de algodão no Brasil para a safra 2025/26, com redução na área plantada e...
PorRedaçãofevereiro 24, 2026 07:05Embrapa confirma primeira detecção de caruru-palmeri em área de grãos em Rancharia, SP
Embrapa confirma primeira detecção de caruru-palmeri em Rancharia, SP. Saiba os impactos na produtividade de soja, milho e algodão, e medidas de prevenção...
PorRedaçãofevereiro 9, 2026 15:13Negócios com algodão seguem lentos em janeiro, mas preço médio mensal avança
Negócios com algodão em pluma seguem lentos em janeiro, mas preços reagem e média mensal sobe 1,08%, segundo análise do Cepea.
PorIuri Castrofevereiro 4, 2026 10:08Sumitomo Chemical expande Expedição de Produtividade para soja, milho e algodão no Brasil
A Sumitomo Chemical expande sua Expedição de Produtividade para soja, milho e algodão no Brasil, com visitas técnicas em mais de 5 milhões...
PorRedaçãofevereiro 4, 2026 07:48Comitê mantém calendário de semeadura do algodão na Bahia para safra 2026/2027
Comitê Técnico Regional mantém calendário de semeadura do algodão na Bahia para safra 2026/2027, alinhando com soja para manejo fitossanitário. Saiba detalhes sobre...
PorRedaçãojaneiro 30, 2026 04:58Preços do algodão reagem com demanda aquecida e oferta retraída no mercado brasileiro
Preços do algodão reagem no Brasil com maior demanda e oferta retraída, mesmo com queda no mercado internacional, segundo o Cepea.
PorIuri Castrojaneiro 28, 2026 10:52Preços do algodão recuam no Brasil e no exterior enquanto nova safra avança
Queda nas cotações reflete oferta elevada, menor interesse comprador e cenário externo pressionado por estoques globais e dólar valorizado Os preços do algodão...
PorIuri Castrojaneiro 21, 2026 16:00Abrapa revela plantio acelerado de algodão apesar de redução na área e exportações recorde
Abrapa revela plantio acelerado de algodão na safra 2025/2026, apesar de redução de 5,5% na área. Exportações batem recorde em dezembro de 2025,...
PorRedaçãojaneiro 21, 2026 04:03Algodão brasileiro consolida posição estratégica com avanços em sustentabilidade e exportações
No encerramento de 2025, a Associação Brasileira dos Produtores de Algodão (Abrapa) divulgou um balanço das conquistas do setor nos últimos 12 meses,...
PorRedaçãodezembro 22, 2025 19:01Mercado de algodão sinaliza desaceleração com foco em carregamentos de fim de ano
Com o final do ano se aproximando, os agentes do mercado de algodão em pluma estão gradativamente se afastando das negociações no balcão,...
PorRedaçãodezembro 17, 2025 09:01Pulgão-do-algodoeiro representa ameaça silenciosa à produtividade agrícola brasileira
Produtores de algodão no Brasil precisam estar vigilantes quanto às infestações iniciais do pulgão-do-algodoeiro (Aphis gossypii), uma das principais pragas que afetam o...
PorRedaçãodezembro 13, 2025 17:01Agronegócio da Bahia fecha safra de algodão 2024/25 com 843 mil toneladas e consolida liderança nacional no cultivo irrigado
Bahia fecha safra 2024/25 com 843 mil t de algodão e mantém alta produtividade com irrigação; projeção 2025/26 indica estabilidade e avanços tecnológicos.
PorIuri Castrodezembro 11, 2025 08:31Oscilações nos preços do algodão em pluma marcam o início de dezembro no Brasil
De acordo com um levantamento recente do Cepea, os preços domésticos do algodão em pluma estão apresentando variações significativas neste começo de dezembro...
PorRedaçãodezembro 10, 2025 11:01Desafios econômicos globais pressionam produção de algodão no Brasil
As projeções do Itaú BBA apontam para uma redução na área plantada de algodão no Brasil na safra 2025/26, influenciada pela desvalorização do...
PorRedaçãodezembro 1, 2025 05:01Mercado de algodão brasileiro demonstra resiliência apesar de desafios globais
O mercado de algodão em pluma no Brasil está exibindo sinais de resistência, impulsionado por estratégias adotadas por vendedores e compradores. De acordo...
PorRedaçãonovembro 19, 2025 12:02Gigante do agronegócio SLC Agrícola firma acordo bilionário com fundos do BTG Pactual
Parceria prevê aporte de cerca de R$ 1 bilhão em sociedades de propósito específico, com foco em irrigação e expansão das fazendas Paladino...
PorRedaçãonovembro 10, 2025 09:36LumiBot: Robô da Embrapa usa luz e inteligência artificial para detectar doenças em algodão e soja
Tecnologia fotônica permite diagnóstico precoce de nematoides e pode reduzir em bilhões as perdas anuais nas lavouras, com uso mais racional de defensivos...
PorIuri Castrooutubro 20, 2025 13:59Algodão brasileiro enfrenta crise de competitividade em meio a turbulências globais
O Indicador do algodão em pluma CEPEA/ESALQ quebrou uma estabilidade de meses ao operar abaixo da paridade de exportação, um cenário não visto...
PorRedaçãooutubro 15, 2025 15:01SLC Agrícola amplia fronteiras com projeto inédito de monitoramento de carbono
Gigante do agronegócio inicia monitoramento em larga escala das emissões e remoções de carbono A SLC Agrícola anunciou a implementação de um projeto...
PorRedaçãosetembro 26, 2025 15:07Safra histórica de algodão em Mato Grosso impulsiona economia rural apesar de desafios nos preços
A safra 2024/25 de algodão em Mato Grosso, o maior produtor nacional da pluma, está prestes a registrar resultados históricos, conforme dados do...
PorRedaçãosetembro 13, 2025 10:01Preços do algodão caem pelo terceiro mês consecutivo no Brasil
Desvalorizações internacionais, chegada da nova safra e necessidade de liquidez por parte dos produtores pressionam o mercado da pluma Os preços do algodão...
PorIuri Castrosetembro 3, 2025 21:02Produtor corta custos, mas multinacionais veem espaço para biológicos com ganho de eficiência
Desafio do setor é convencer produtores da importância estratégica desses insumos, que prometem ganhos de eficiência e sustentabilidade no campo Mercado em expansão...
PorIuri Castrosetembro 3, 2025 07:20Imagem viral mostra como o Matopiba cresce no algodão com sustentabilidade
Uma imagem viralizada nas redes resume bem a transformação do Matopiba: de um lado, vegetação nativa intacta; do outro, uma lavoura de algodão...
PorIuri Castroagosto 25, 2025 21:46Produção de algodão no oeste da Bahia supera expectativas apesar de seca prolongada
A produção de algodão no oeste da Bahia tem surpreendido positivamente os agricultores locais, mesmo após um período de seca que comprometeu o...
PorRedaçãoagosto 25, 2025 08:42Jerônimo Rodrigues prestigia comemoração dos 25 anos da Abapa em Luís Eduardo Magalhães
O governador da Bahia, Jerônimo Rodrigues, participou neste sábado (16) da celebração dos 25 anos da Associação Baiana dos Produtores de Algodão (Abapa),...
PorRedaçãoagosto 17, 2025 11:10Notícias recentes
Preço da melancia recua em maio com clima frio reduzindo consumo no Brasil
maio 15, 2026 18:00Preços da manga reagem no Vale do São Francisco após redução na oferta
maio 15, 2026 17:00Mercado da maçã perde ritmo com queda nas temperaturas e demanda mais fraca
maio 15, 2026 16:00Preço da cenoura segue elevado em São Gotardo mesmo com demanda mais lenta
maio 15, 2026 15:00Categorias
- Açúcar1
- Agricultura816
- Agro Trends Premium5
- Alface2
- Algodão27
- Arroz19
- Aves60
- Bahia34
- Bahia Agro Vagas4
- Bahia Farm Show2
- Banana1
- Batata1
- Boi233
- Bolsa de valores47
- Brasil365
- Cacau24
- Café106
- Cana-de-açúcar1
- Cebola1
- Citrus7
- Clima205
- Colunistas3
- Commodities1
- Cotações97
- Economia547
- Energia51
- Especialistas43
- Eunápolis1
- Eventos64
- Exportações2
- Feijão11
- Geral150
- Inovação166
- Irrigação15
- Jaborandi1
- Leite68
- Livros2
- Maçã1
- Mamão2
- Mandioca6
- Manga6
- Máquina Agrícola1
- Melancia1
- Melão2
- Mercado3
- Milho49
- Mundo76
- Pecuária337
- Peixe30
- Plantão Policial10
- Safra2
- Soja263
- Suínos25
- Tecnologia2
- Tecnologia81
- Tomate4
- Trigo41
- Uva4
- Vaga de Emprego2